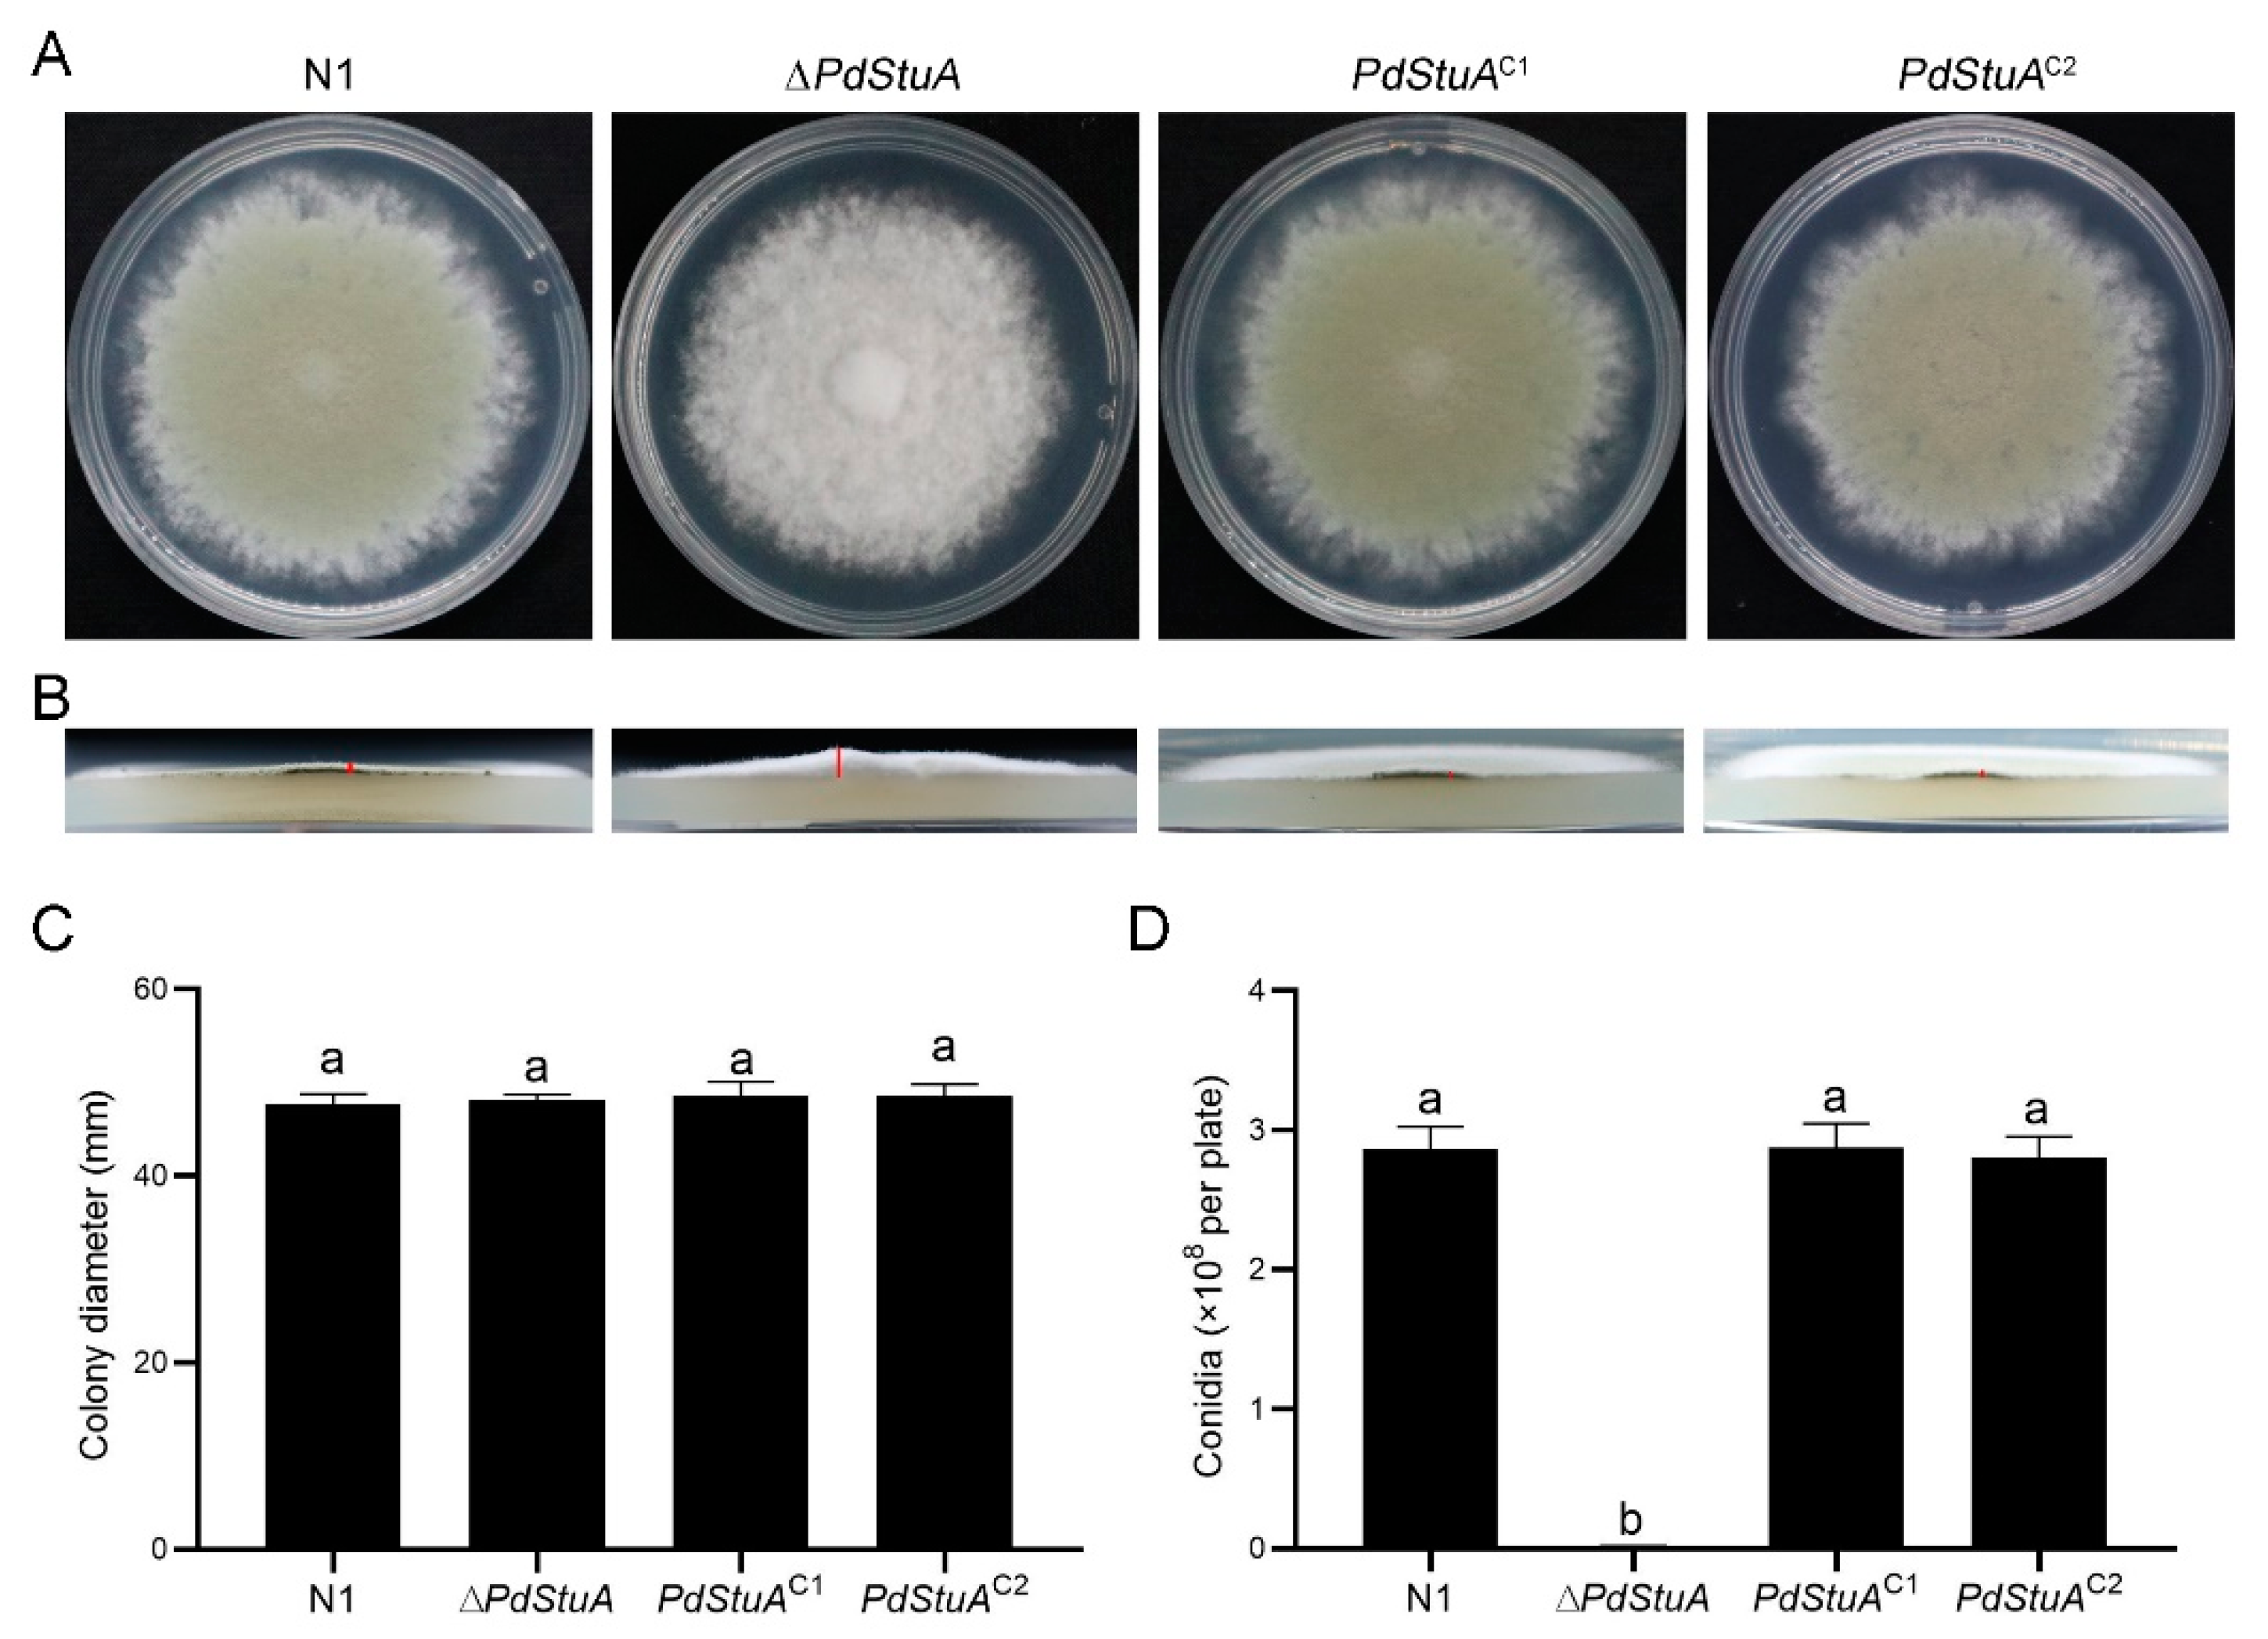
Jof 09 00941 g003
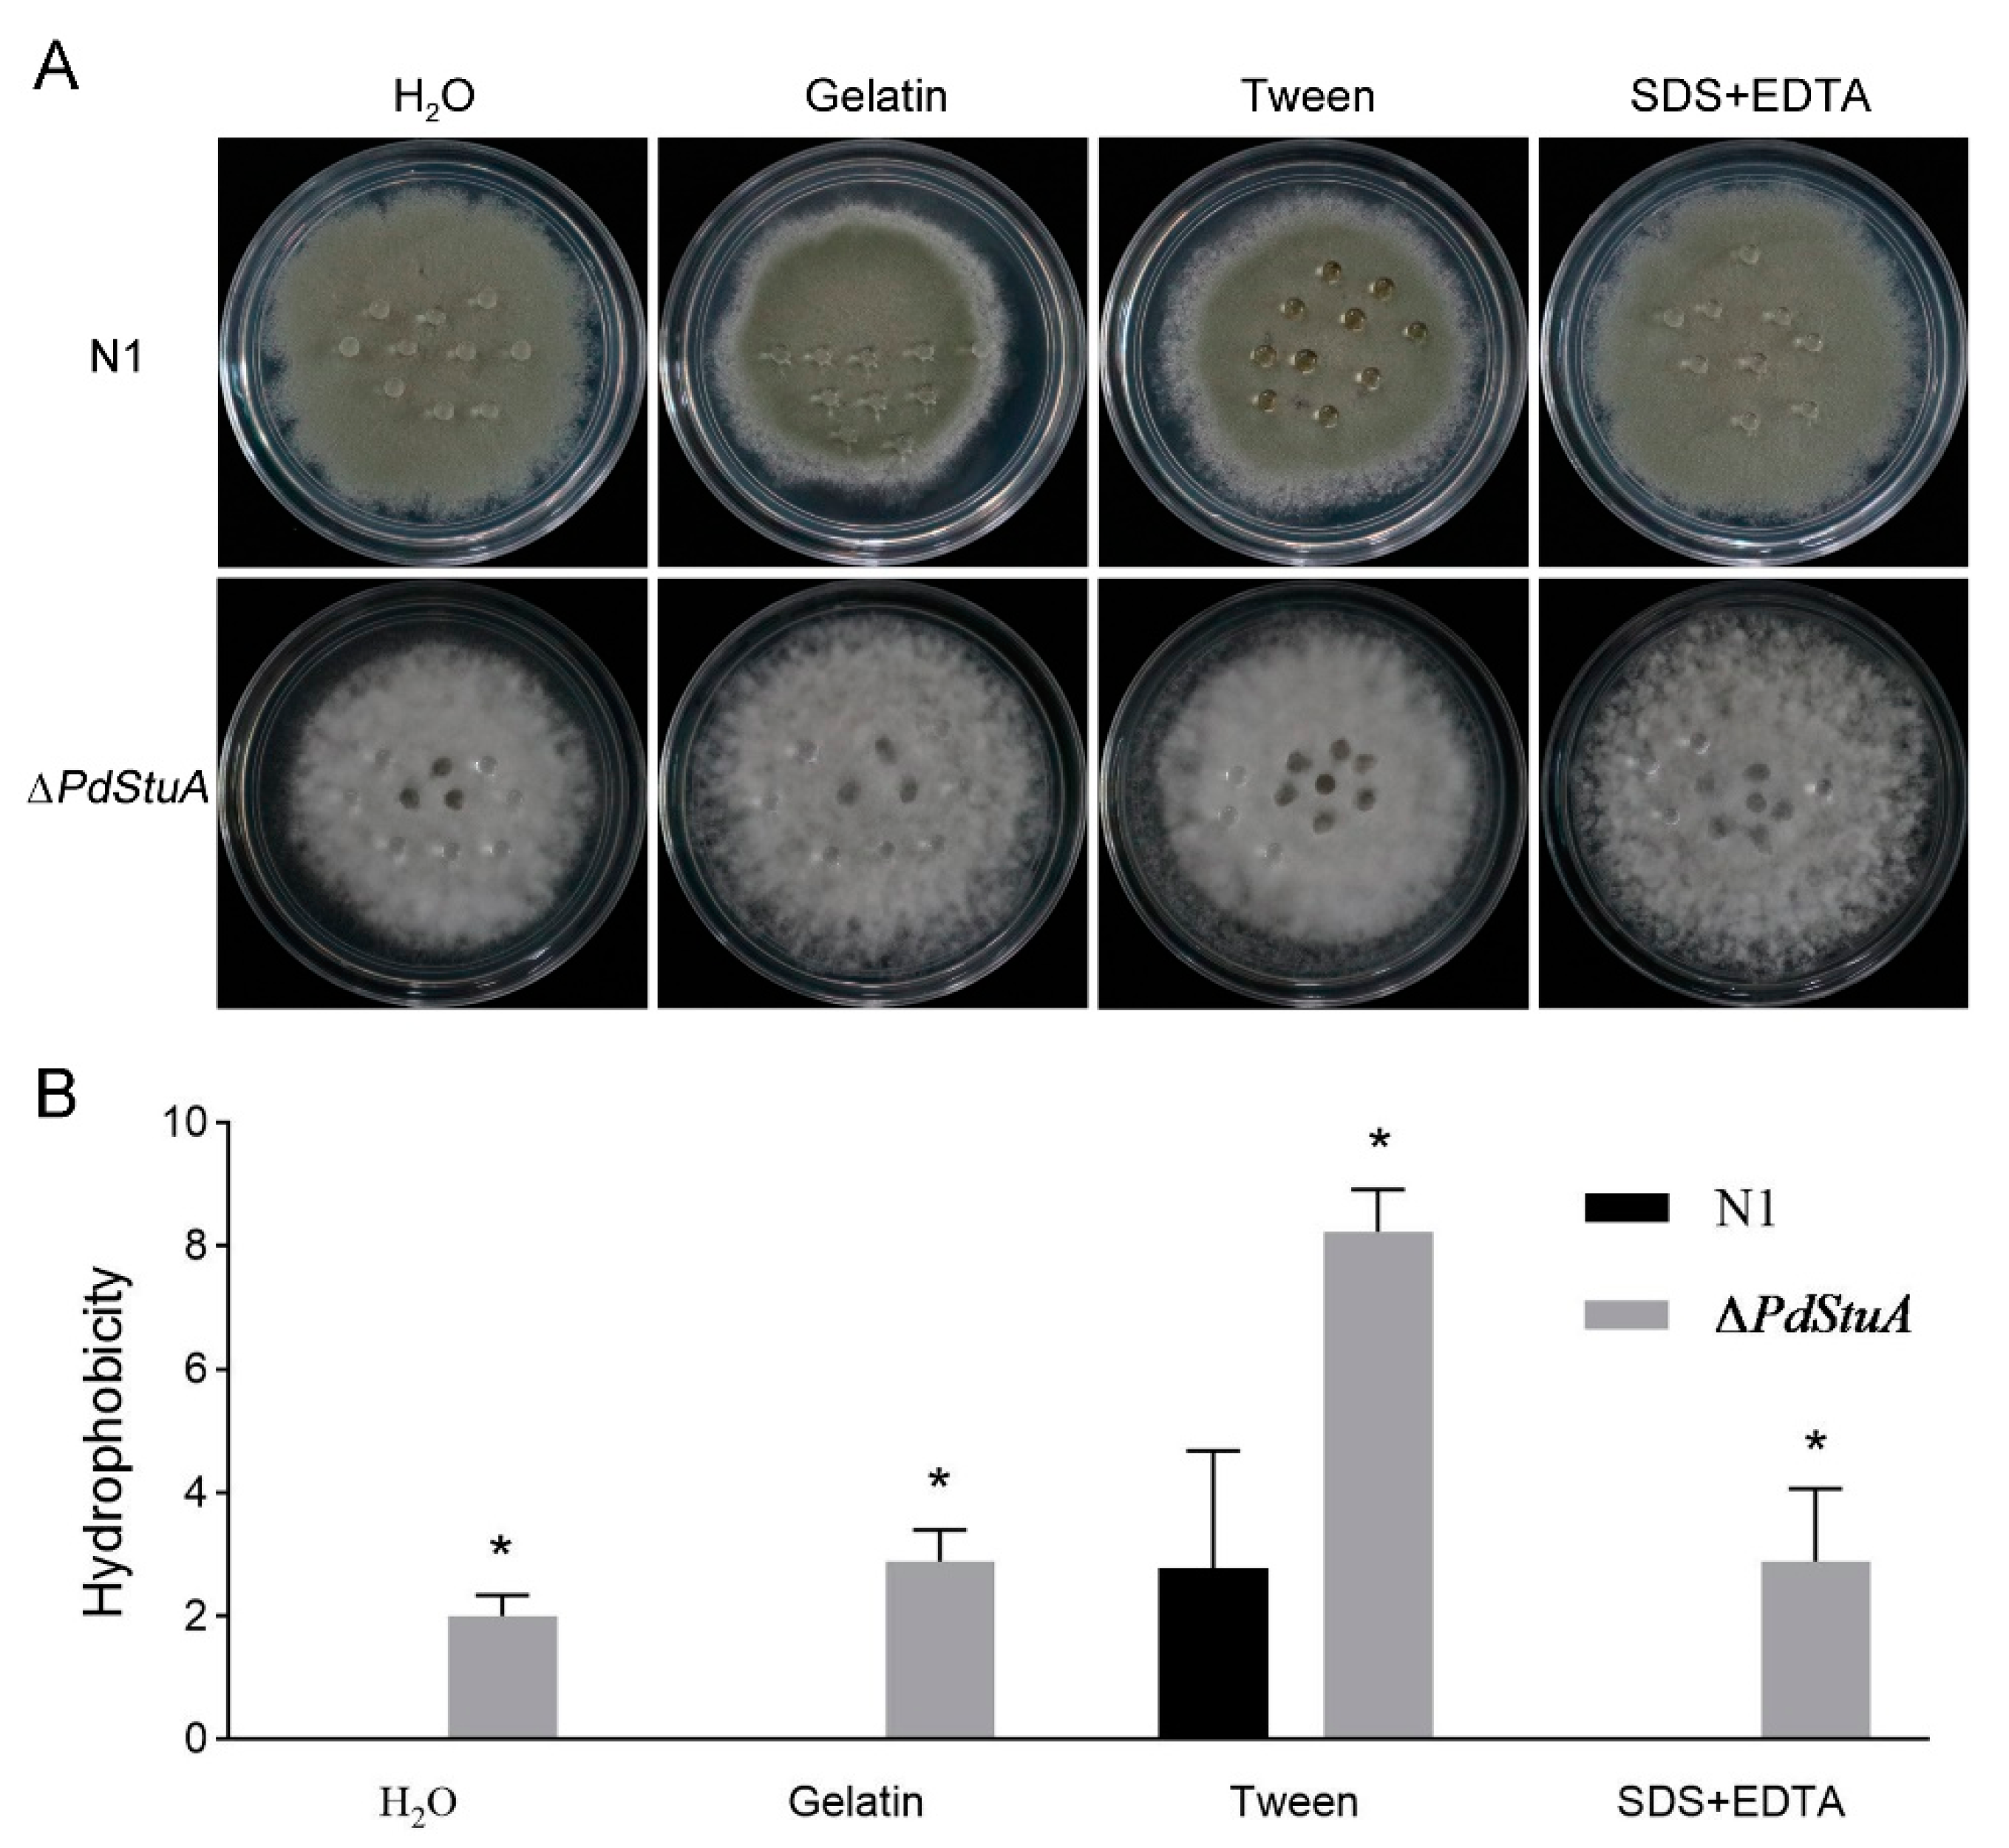
Jof 09 00941 g005

PdStuA Is a Key Transcription Factor Controlling Sporulation, Hydrophobicity, and Stress Tolerance in Penicillium digitatum
Abstract
:1. Introduction
2. Materials and Methods
2.1. Fungal Strains and Culture Conditions
2.2. Targeted Gene Disruption and Complementation
2.3. Phylogenetic Analysis
2.4. Phenotypic Analysis and Subcellular Organelle Observation
2.5. Stress Tolerance Assays
2.6. Virulence Assays
2.7. Quantitative Real-Time PCR Assays (RT-qPCR)
2.8. Statistical Analysis
3. Results
3.1. Summary of PdStuA in P. digitatum
3.2. Construction and Verification of PdStuA-Deletion and PdStuA-Complementation Mutants
3.3. PdStuA Affects Spore Production but Does Not Affect Hyphal Development
3.4. PdStuA Controls the Occurrence of Conidiophores
3.5. PdStuA Is Involved in Hyphal Hydrophobicity in P. digitatum
3.6. PdStuA Takes Part in Cell Wall Integrity
3.7. PdStuA Is Essential for Stress Responses
3.8. Expression Change for Transcription
3.9. PdStuA Does Not Affect the Pathogenicity of P. digitatum
4. Discussion
Supplementary Materials
Author Contributions
Funding
Institutional Review Board Statement
Informed Consent Statement
Data Availability Statement
Acknowledgments
Conflicts of Interest
References
- Cheng, X.M.; Yang, Y.; Zhu, X.R.; Yuan, P.; Gong, B.Y.; Ding, S.G.; Shan, Y. Inhibitory mechanisms of cinnamic acid on the growth of Geotrichum citri-aurantii. Food Control 2022, 131, 108459. [Google Scholar] [CrossRef]
- Kahramanoglu, A.; Nisar, M.F.; Chen, C.Y.; Usanmaz, S.; Chen, J.Y.; Wan, C.P. Light: An alternative method for physical control of postharvest rotting caused by fungi of citrus fruit. J. Food Qual. 2020, 2020, 8821346. [Google Scholar] [CrossRef]
- Reymick, O.O.; Liu, D.Z.; Cheng, Y.; Ouyang, Q.L.; Tao, N.G. Cuminaldehyde-induced oxidative stress inhibits growth of Penicillium digitatum in citrus. Postharvest Biol. Technol. 2022, 192, 111991. [Google Scholar] [CrossRef]
- Du, Y.J.; Sun, J.C.; Tian, Z.H.; Cheng, Y.J.; Long, C.A. Effect of blue light treatments on Geotrichum citri-aurantii and the corresponding physiological mechanisms of citrus. Food Control 2023, 145, 109468. [Google Scholar] [CrossRef]
- Bhatta, U.K. Alternative management approaches of citrus diseases caused by Penicillium digitatum (green mold) and Penicillium italicum (blue mold). Front. Plant Sci. 2022, 12, 833328. [Google Scholar] [CrossRef] [PubMed]
- Wang, M.S.; Sun, X.P.; Zhu, C.Y.; Xu, Q.; Ruan, R.X.; Yu, D.L.; Li, H.Y. Pdbr1A, PdabaA and PdwetA control distinct stages of conidiogenesis in Penicillium digitatum. Res. Microbiol. 2015, 166, 56–65. [Google Scholar] [CrossRef]
- Cho, H.J.; Son, S.H.; Chen, W.P.; Son, Y.E.; Lee, I.; Yu, J.H.; Park, H.S. Regulation of conidiogenesis in Aspergillus flavus. Cells 2022, 11, 2796. [Google Scholar] [CrossRef]
- Chung, D.; Upadhyay, S.; Bomer, B.; Wilkinson, H.H.; Ebbole, D.J.; Shaw, B.D. Neurospora crassa ASM-1 complements the conidiation defect in a stuA mutant of Aspergillus nidulans. Mycologia 2015, 107, 298–306. [Google Scholar] [CrossRef]
- Zhu, C.Y.; Wang, Y.Y.; Hu, X.; Lei, M.Y.; Wang, M.S.; Zeng, J.W.; Li, H.Y.; Liu, Z.Y.; Zhou, T.; Yu, D.L. Involvement of LaeA in the regulation of conidia production and stress responses in Penicillium digitatum. J. Basic Microbiol. 2020, 60, 82–88. [Google Scholar] [CrossRef]
- Yang, F.; Cheng, L.T.; Du, Y.L.; Xia, L.G.; Long, C.A. Functional identification of the DHN melanin synthesis gene cluster and its role in UV-C tolerance in citrus postharvest pathogenic fungus Penicillium digitatum. Fungal Biol. 2022, 126, 566–575. [Google Scholar] [CrossRef]
- Martins-Santana, L.; Petrucelli, M.F.; Sanches, P.R.; Martinez-Rossi, N.M.; Rossi, A. Peptidase regulation in Trichophyton rubrum is mediated by the synergism between alternative splicing and StuA-dependent transcriptional mechanisms. Front. Microbiol. 2022, 13, 930398. [Google Scholar] [CrossRef]
- Bitencourt, T.A.; Neves-da-Rocha, J.; Martins, M.P.; Sanches, P.R.; Lang, E.A.S.; Bortolossi, J.C.; Rossi, A.; Martinez-Rossi, N.M. StuA-regulated processes in the dermatophyte Trichophyton rubrum: Transcription profile, cell-cell adhesion, and immunomodulation. Front. Cell. Infect. Microbiol. 2021, 11, 643659. [Google Scholar] [CrossRef]
- Rath, M.; Crenshaw, N.J.; Lofton, L.W.; Glenn, A.E.; Gold, S.E. FvSTUA is a key regulator of sporulation, toxin synthesis, and virulence in Fusarium verticillioides. Mol. Plant-Microbe Interact. 2020, 33, 958–971. [Google Scholar] [CrossRef] [PubMed]
- Lang, E.A.S.; Bitencourt, T.A.; Peres, N.T.A.; Lopes, L.; Silva, L.G.; Cazzaniga, R.A.; Rossi, A.; Martinez-Rossi, N.M. The stuA gene controls development, adaptation, stress tolerance, and virulence of the dermatophyte Trichophyton rubrum. Microbiol. Res. 2020, 241, 126592. [Google Scholar] [CrossRef] [PubMed]
- Xie, M.H.; Wang, Y.C.; Tang, L.Y.; Yang, L.; Zhou, D.X.; Li, Q.; Niu, X.M.; Zhang, K.Q.; Yang, J.K. AoStuA, an APSES transcription factor, regulates the conidiation, trap formation, stress resistance and pathogenicity of the nematode-trapping fungus Arthrobotrys oligospora. Environ. Microbiol. 2019, 21, 4648–4661. [Google Scholar] [CrossRef] [PubMed]
- Lysoe, E.; Pasquali, M.; Breakspear, A.; Kistler, H.C. The transcription factor FgStuAp influences spore development, pathogenicity, and secondary metabolism in Fusarium graminearum. Mol. Plant-Microbe Interact. 2011, 24, 54–67. [Google Scholar] [CrossRef] [PubMed]
- Kang, E.H.; Kim, J.A.; Oh, H.W.; Park, H.M. LAMMER kinase LkhA plays multiple roles in the vegetative growth and asexual and sexual development of Aspergillus nidulans. PLoS ONE 2013, 8, 0058762. [Google Scholar] [CrossRef] [PubMed]
- Miller, K.Y.; Toennis, T.M.; Adams, T.H.; Miller, B.L. Isolation and transcriptional characterization of a morphological modifier the Aspergillus nidulans stunted (stuA) gene. Mol. Gen. Genet. 1991, 227, 285–292. [Google Scholar] [CrossRef]
- Ohara, T.; Tsuge, T. FoSTUA, encoding a basic helix-loop-helix protein, differentially regulates development of three kinds of asexual spores, macroconidia, microconidia, and chlamydospores, in the fungal plant pathogen Fusarium oxysporum. Eukaryot. Cell 2004, 3, 1412–1422. [Google Scholar] [CrossRef] [PubMed]
- Soyer, J.L.; Hamiot, A.; Ollivier, B.; Balesdent, M.H.; Rouxel, T.; Fudal, I. The APSES transcription factor LmStuA is required for sporulation, pathogenic development and effector gene expression in Leptosphaeria maculans. Mol. Plant Pathol. 2015, 16, 1000–1005. [Google Scholar] [CrossRef]
- Tiley, A.M.M.; Foster, G.D.; Bailey, A.M. Exploring the genetic regulation of asexual sporulation in Zymoseptoria tritici. Front. Microbiol. 2018, 9, 01859. [Google Scholar] [CrossRef] [PubMed]
- Pasquali, M.; Spanu, F.; Scherm, B.; Balmas, V.; Hoffmann, L.; Hammond-Kosack, K.E.; Beyer, M.; Migheli, Q. FcStuA from Fusarium culmorum controls wheat foot and root rot in a toxin dispensable manner. PLoS ONE 2013, 8, 0057429. [Google Scholar] [CrossRef] [PubMed]
- Chen, Y.; Li, B.; Xu, X.; Zhang, Z.; Tian, S. The pH-responsive PacC transcription factor plays pivotal roles in virulence and patulin biosynthesis in Penicillium expansum. Environ. Microbiol. 2018, 20, 4063–4078. [Google Scholar] [CrossRef] [PubMed]
- Yang, W.J.; Wu, H.; Wang, Z.X.; Sun, Q.; Qiao, L.T.; Huang, B. The APSES gene MrStuA regulates sporulation in Metarhizium robertsii. Front. Microbiol. 2018, 9, 01208. [Google Scholar] [CrossRef] [PubMed]
- Xu, X.D.; Chen, Y.; Li, B.Q.; Tian, S.P. Arginine methyltransferase PeRmtC regulates development and pathogenicity of Penicillium expansum via mediating key genes in conidiation and secondary metabolism. J. Fungi 2021, 7, 807. [Google Scholar] [CrossRef]
- Fu, H.L.; Chung, K.R.; Gai, Y.P.; Mao, L.J.; Li, H.Y. The basal transcription factor II H subunit Tfb5 is required for stress response and pathogenicity in the tangerine pathotype of Alternaria alternata. Mol. Plant Pathol. 2020, 21, 1337–1352. [Google Scholar] [CrossRef]
- Liu, P.; Cheng, Y.J.; Yang, M.; Liu, Y.J.; Chen, K.; Long, C.A.; Deng, X.X. Mechanisms of action for 2-phenylethanol isolated from Kloeckera apiculata in control of Penicillium molds of citrus fruits. BMC Microbiol. 2014, 14, 242. [Google Scholar] [CrossRef]
- Yuchao, Z.; Yanping, F.; Chaoxi, L.; Fuxing, Z. Pyrimethanil sensitivity and resistance mechanisms in Penicillium digitatum. Plant Dis. 2021, 105, 1758–1764. [Google Scholar]
- Tian, Z.H.; Chen, C.W.; Chen, K.; Liu, P.; Fan, Q.J.; Zhao, J.; Long, C.A. Biocontrol and the mechanisms of Bacillus sp. w176 against postharvest green mold in citrus. Postharvest Biol. Technol. 2020, 159, 111022. [Google Scholar] [CrossRef]
- Livak, K.J.; Schmittgen, T.D. Analysis of relative gene expression data using real-time quantitative PCR and the 2−ΔΔCT method. Methods 2001, 25, 402–408. [Google Scholar] [CrossRef]
- Lin, C.J.; Sasse, C.; Gerke, J.; Valerius, O.; Irmer, H.; Frauendorf, H.; Heinekamp, T.; Strassburger, M.; Tran, V.T.; Herzog, B.; et al. Transcription factor SomA is required for adhesion, development and virulence of the human pathogen Aspergillus fumigatus. PLoS Pathog. 2015, 11, 1005205. [Google Scholar] [CrossRef] [PubMed]
- Miller, K.Y.; Wu, J.G.; Miller, B.L. StuA is required for cell pattern formation in Aspergillus. Genes Dev. 1992, 6, 1770–1782. [Google Scholar] [CrossRef] [PubMed]
- Dutton, J.R.; Johns, S.; Miller, B.L. StuAp is a sequence-specific transcription factor that regulates developmental complexity in Aspergillus nidulans. EMBO J. 1997, 16, 5710–5721. [Google Scholar] [CrossRef] [PubMed]
- Brown, N.A.; Ries, L.N.A.; Reis, T.F.; Rajendran, R.; dos Santos, R.A.C.; Ramage, G.; Riano-Pachon, D.M.; Goldman, G.H. RNAseq reveals hydrophobins that are involved in the adaptation of Aspergillus nidulans to lignocellulose. Biotechnol. Biofuels 2016, 9, 145. [Google Scholar] [CrossRef]
- Zhang, S.Z.; Xia, Y.X.; Kim, B.; Keyhani, N.O. Two hydrophobins are involved in fungal spore coat rodlet layer assembly and each play distinct roles in surface interactions, development and pathogenesis in the entomopathogenic fungus, Beauveria bassiana. Mol. Microbiol. 2011, 80, 811–826. [Google Scholar] [CrossRef]
- Miao, P.F.; Mao, X.Z.; Chen, S.; Abubakar, Y.S.; Li, Y.L.; Zheng, W.H.; Zhou, J.; Wang, Z.H.; Zheng, H.W. The mitotic exit mediated by small GTPase Tem1 is essential for the pathogenicity of Fusarium graminearum. PLoS Pathog. 2023, 19, 1011255. [Google Scholar] [CrossRef]
- Lim, J.-Y.; Jung, Y.-E.; Hwang, H.-E.; Kim, C.-H.; Basaran-Akgul, N.; Goli, S.H.; Templeton, S.P.; Park, H.-M. Survival Factor A (SvfA) Contributes to Aspergillus nidulans Pathogenicity. J. Fungi 2023, 9, 143. [Google Scholar] [CrossRef]
- Choo, C.Y.L.; Wu, P.C.; Yago, J.I.; Chung, K.R. The Pex3-mediated peroxisome biogenesis plays a critical role in metabolic biosynthesis, stress response, and pathogenicity in Alternaria alternata. Microbiol. Res. 2023, 266, 127236. [Google Scholar] [CrossRef]
- Wang, Z.L.; Zhang, L.B.; Ying, S.H.; Feng, M.G. Catalases play differentiated roles in the adaptation of a fungal entomopathogen to environmental stresses. Environ. Microbiol. 2013, 15, 409–418. [Google Scholar] [CrossRef]

Disclaimer/Publisher’s Note: The statements, opinions and data contained in all publications are solely those of the individual author(s) and contributor(s) and not of MDPI and/or the editor(s). MDPI and/or the editor(s) disclaim responsibility for any injury to people or property resulting from any ideas, methods, instructions or products referred to in the content. |
© 2023 by the authors. Licensee MDPI, Basel, Switzerland. This article is an open access article distributed under the terms and conditions of the Creative Commons Attribution (CC BY) license (https://creativecommons.org/licenses/by/4.0/).
Share and Cite
Du, Y.; Zhu, J.; Tian, Z.; Long, C. PdStuA Is a Key Transcription Factor Controlling Sporulation, Hydrophobicity, and Stress Tolerance in Penicillium digitatum. J. Fungi 2023, 9, 941. https://doi.org/10.3390/jof9090941
Du Y, Zhu J, Tian Z, Long C. PdStuA Is a Key Transcription Factor Controlling Sporulation, Hydrophobicity, and Stress Tolerance in Penicillium digitatum. Journal of Fungi. 2023; 9(9):941. https://doi.org/10.3390/jof9090941
Chicago/Turabian StyleDu, Yujie, Jinfan Zhu, Zhonghuan Tian, and Chaoan Long. 2023. "PdStuA Is a Key Transcription Factor Controlling Sporulation, Hydrophobicity, and Stress Tolerance in Penicillium digitatum" Journal of Fungi 9, no. 9: 941. https://doi.org/10.3390/jof9090941
APA StyleDu, Y., Zhu, J., Tian, Z., & Long, C. (2023). PdStuA Is a Key Transcription Factor Controlling Sporulation, Hydrophobicity, and Stress Tolerance in Penicillium digitatum. Journal of Fungi, 9(9), 941. https://doi.org/10.3390/jof9090941

